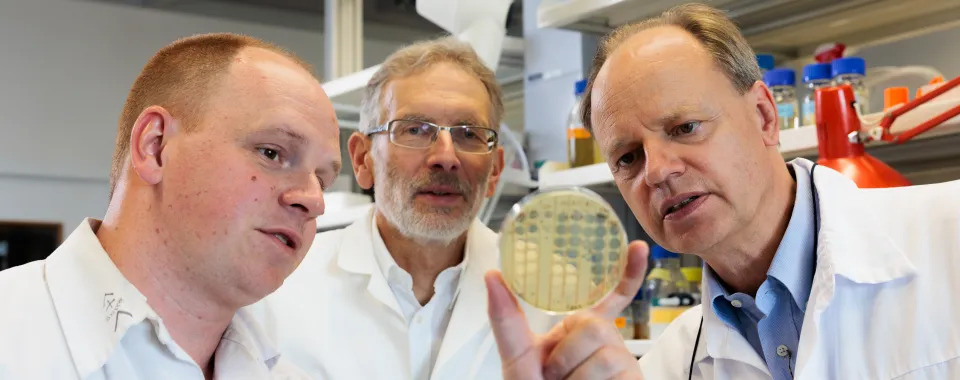
Bactériophages : De droite à gauche : Christian van Delden, Thilo Köhler et Alexandre Luscher - Copyright : Jonathan Imhof/ HUG

Une équipe multidisciplinaire des Hôpitaux universitaires de Genève (HUG) et de l’Université de Genève (UNIGE) est parvenue pour la première fois, à l’aide de bactériophages, à traiter avec succès un patient souffrant d’une infection bactérienne pulmonaire chronique résistante aux antibiotiques. Cette première suisse a été réalisée grâce à une approche multidisciplinaire et hautement personnalisée consistant à sélectionner un bactériophage (virus qui s’attaque aux bactéries) spécifique aux bactéries multirésistantes du patient. Les phages font partie des stratégies envisagées pour combattre le fléau de l’antibiorésistance bactérienne. Toutefois, il reste beaucoup à faire afin de sélectionner ceux qui sont spécifiques à chaque personne, établir les protocoles de traitements, connaître les effets secondaires et éviter l’émergence de souches résistantes aux phages. Ces résultats font l’objet d’une publication dans la revue Nature Communications.
Un traitement non conventionnel
Dans cette publication, une équipe des HUG et de l’UNIGE a utilisé la phagothérapie pour traiter avec succès un patient de 41 ans souffrant d’une atteinte pulmonaire chronique avec une souche multirésistante de la bactérie Pseudomonas aeruginosa. Après six mois d’hospitalisation aux HUG, totalement dépendant d’une antibiothérapie intraveineuse en continu et sans perspective d’amélioration, le patient a reçu un traitement expérimental de dernier recours par phages autorisé à titre compassionnel. Grâce à celui-ci, il a finalement pu quitter l’hôpital, retrouver son autonomie et reprendre son travail.
La phagothérapie est une approche qui utilise des bactériophages, dits aussi phages, pour combattre les infections bactériennes. Pour les bactéries, ceux-ci sont des « virus naturels » capables de cibler des souches bactériennes spécifiques sans infecter les cellules humaines. Utilisés en combinaison avec des antibiotiques, ils contournent la résistance aux antibiotiques. Bien que cette stratégie soit prometteuse, des données fondamentales scientifiques et cliniques sont encore nécessaires pour développer des traitements efficaces, sans danger et approuvés par les autorités sanitaires, ce qui n’est pas encore le cas aujourd’hui.
Une approche thérapeutique hautement individualisée
« Les bactéries peuvent développer des résistances aux phages comme aux antibiotiques. Afin d’augmenter nos chances de succès thérapeutique, il était donc crucial de sélectionner le phage approprié pour la souche bactérienne infectant spécifiquement le patient avant la phagothérapie » souligne le Dr Thilo Köhler, co-responsable du groupe de recherche au Département de microbiologie et de médecine moléculaire de la Faculté de médecine de l’UNIGE. Pour ce faire, l’équipe des HUG et de l’UNIGE a d’abord isolé les bactéries des sécrétions respiratoires du patient, puis a déterminé le type de bactéries présentes, leur profil génétique et leur résistance tant aux antibiotiques qu’à une banque de phages. Après une recherche intensive, mais vaine dans les banques de phages des HUG, du CHUV et du Centre européen de phages de l’Hôpital militaire Reine Astride à Bruxelles, soit des centaines de phages différents, un phage actif sur les bactéries du patient a finalement été identifié à l’Université de Yale aux États-Unis.
L’efficacité sans effets adverses
Les phages ont été administrés par aérosols tout en maintenant les antibiotiques intraveineux. L’amélioration du patient a été spectaculaire et ceci sans aucun effet secondaire, confirmant l’efficacité et l’innocuité des phages. Le suivi détaillé des bactéries et phages dans les sécrétions du patient prouve la réplication du phage limitée à sa cible bactérienne sans émergence de bactéries plus résistantes ni plus dangereuses. « Toutefois, il est important de souligner que la phagothérapie est utilisée en complément de l’antibiothérapie et non en remplacement », insiste le Pr Christian van Delden, médecin adjoint agrégé au Service des maladies infectieuses des HUG et professeur ordinaire au Département de médecine de la Faculté de médecine de l’UNIGE, avant de souligner l’importance de la recherche de nouvelles stratégies pour lutter contre l’antibiorésistance. Il met en avant le succès de l’approche translationnelle utilisée : partant du patient, en passant par le laboratoire, pour revenir au patient. L’équipe genevoise salue aussi la collaboration avec le groupe américain qui a généreusement fourni les phages sans contrepartie. Christian van Delden le confirme : « sans eux, cette vie n’aurait pas pu être sauvée ».
Lutter contre la résistance aux antibiotiques
L’antibiorésistance est une urgence sanitaire mondiale causant des millions de décès dans le monde chaque année, 1,7 million en 2019 selon l’Organisation mondiale de la santé. Ce fléau est principalement dû aux propriétés intrinsèques des bactéries. En effet, dans la nature, comme dans le corps humain, celles-ci forment un écosystème avec leurs ennemis, à savoir d’autres espèces bactériennes, des champignons et des bactériophages. Pour y faire face, les bactéries possèdent une capacité naturelle à évoluer rapidement par mutations, leur permettant non seulement de s’adapter à leur environnement, mais également d’échapper aux antibiotiques. Ainsi, l’exposition prolongée ou répétée aux antibiotiques conduit automatiquement à la sélection de souches bactériennes résistantes. La thérapie par phages est une des stratégies prometteuses pour contourner ce problème de santé majeur.
DOI : 10.1038/s41467-023-39370-z
HUG, Service de presse et relations publiques
presse-hug@hug.ch
+41 22 372 37 37
UNIGE, Service des médias
media@unige.ch
+41 22 379 77 96